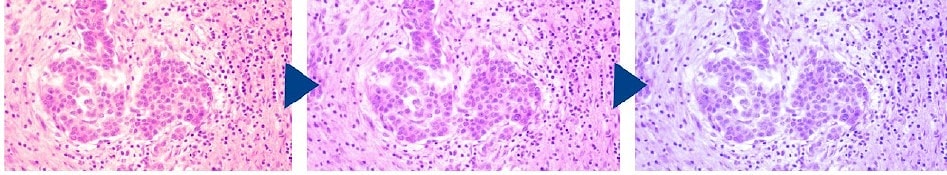

Прямой микроскоп Nexcope NE700

Современный микроскоп Nexcope NE700 для профессиональной лаборатории. Усовершенствованная оптическая система с возможностью использования план-ахроматических объективов с высокой числовой апертурой позволяет реализовать любую методику на данном микроскопе.
Отличительные особенности Nexcope NE700
Апохроматическая оптика
Оптическая система NIS Infinity обеспечивает отличную расширяемость для реализации разнообразных методик на базе этого микроскопа. А благодаря технологии многослойного покрытия появилась возможность использования план-апохроматических объективов с высокой числовой апертурой для получения изображения наилучшего разрешения.
Освещение
Светодиодный источник света создает условия дневного освещения, благодаря чему образец имеет естественный цвет. Срок службы светодиода составляет 50 000 часов, что не только снижает затраты на обслуживание, но и сохраняет яркость стабильной во время использования.
Умная система автоматически запоминает и устанавливает уровень интенсивности освещения для каждого из объективов при переключении увеличений.
Экран состояния
На экране, расположенном на передней части микроскопа, отображается состояние микроскопа, выбранный объектив, яркость, а также цветовая температура света, которую теперь тоже можно регулировать!
Обычно светодиодные источники света излучают холодный свет, непривычный пользователям микроскопам с галогеновым осветителем. Однако теперь появилась возможность сделать свет более тёплым, в зависимости от ваших предпочтений!
Технические характеристики Nexcope NE700
| Оптическая система | Бесконечная оптическая система |
| Окуляры | Увеличения 10х, поле зрения 22 мм. Регулировка диоптрий -5 ~ +5 |
| Тубус | Бинокулярный тубус c углом наклона 30 градусов; вращение на 360 градусов; регулировка мезжрачкового расстояния 47 - 78 мм |
| Тринокулярный тубус c углом наклона 30 градусов; регулировка межзрачкового расстояния 47 - 78 мм; распределение светового потока окуляры/камера - 50/50 | |
| Тринокулярный тубус c углом наклона 30 градусов; регулировка межзрачкового расстояния 47 - 78 мм; распределение светового потока окуляры/камера - 100/00 | |
| Бинокулярный тубус со встроенной камерой и углом наклона 30 градусов, передача данных по WiFi; регулировка межзрачкового расстояния 47 - 78 мм | |
| Объективы | План ахроматические объективы (4х, 10х, 20х, 40х, 100х) |
| План ахроматические фазовые объективы (10х, 20х, 40х, 100х) | |
| План апохроматические объективы (4х, 10х, 20х, 40х, 100х) | |
| Револьвер | Пятипозиционный с определением положения объектива |
| Столик | Безреечный столик 235х150 мм, диапазон перемещения 78х54 мм; обработка для устойчивости к реагентам (опция - закалённое стекло) |
| Адаптеры камеры | 0.35х/0.5х/0.65х/1х С-mount |
| Конденсор | Конденсор Аббе (NA 0.9) с ирисовой диафрагмой |
| Откидной ахроматический конденсор (NA 0.9/0.25) с ирисовой диафрагмой | |
| Конденсор Аббе (NA 1.25) с турелью фазового контраста | |
| Конденсор (NA 1.3-1.26) масляный для тёмного поля | |
| Конденсор (NA 0.7-0.9) сухой для тёмного поля | |
| Фокусировка | Коаксиальная точная и грубая фокусировка, диапазон 28 мм, точная фокусировка 0,001 мм |
| Освещение | Проходящее: светодиодное 3W; умная система освещения, регулировка температуры света |
| Флуоресцентное: светодиодное, 3 волны излучения; 4-х позиционная турель флуоресцентных кубиков с ирисовой диафрагмой | |
| Адаптеры камеры | 1х, 0.5х, настраиваемая фокусировка |
| Аксессуары | Набор для простой поляризации |
| Реализуемые методики | Светлое поле, фазовый контраст, тёмное поле, флуоресценция, простая поляризация |
У нас Вы можете купить микроскоп Nexcope NE700 или обратиться для консультации по любому вопросу, связанному с микроскопами Nexcope.
Приглашаем посетить нашу фотогалерею микроскопов, где вы можете увидеть результаты нашей работы.
Производитель
Nexcope













